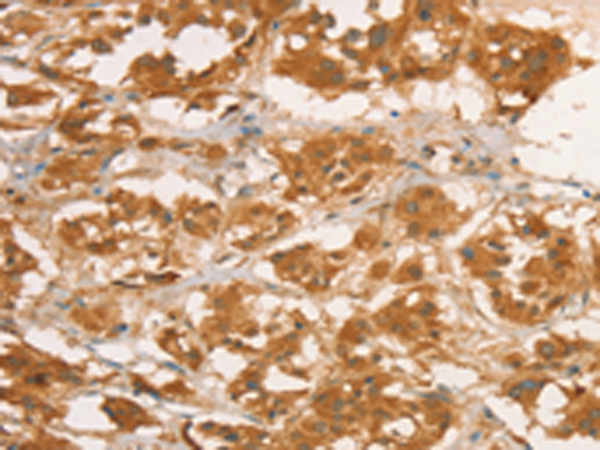
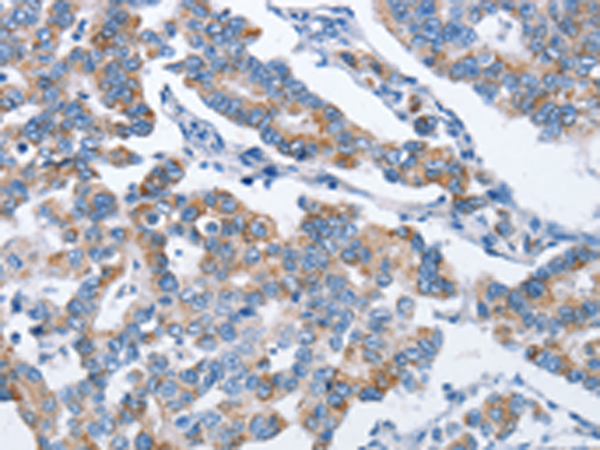
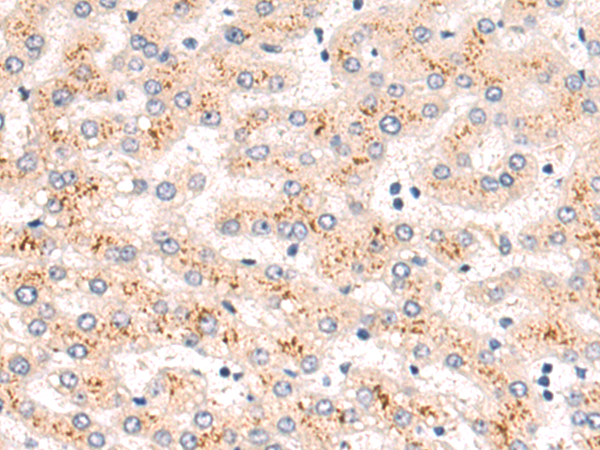
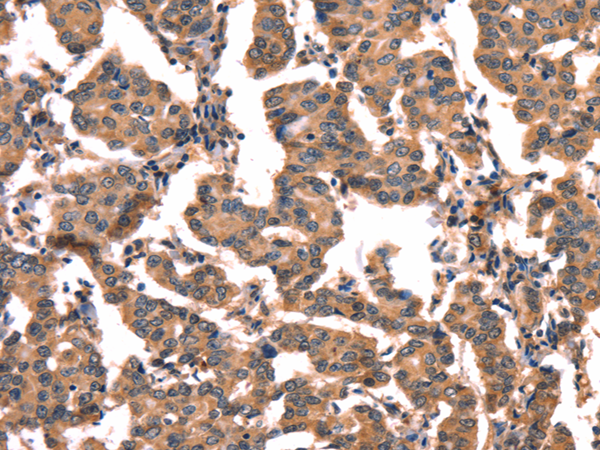

-
分类: 科研抗体货号: P08193别名: CYP3; CypD; CyP-M; Cyp-D应用: WB,IHC反应种属: Human, Mouse, Rat
-
分类: 科研抗体货号: P08175别名: CPB; PASP; PCPB应用: IHC反应种属: Human, Rat
-
分类: 科研抗体货号: P08154别名:应用: WB,IHC反应种属: Human, Mouse, Rat
-
分类: 科研抗体货号: P08192别名: OI9; CYPB; SCYLP; CYP-S1应用: WB,IHC反应种属: Human, Mouse, Rat
-
分类: 科研抗体货号: P08173别名: HCRNN4应用: WB,IHC反应种属: Human, Mouse
-
分类: 科研抗体货号: P08153别名: CGB; CGB5; CGB7; CGB8; hCGB应用: WB,IHC反应种属: Human
-
分类: 科研抗体货号: P08189别名: C10orf66; bA18I14.5应用: WB,IHC反应种属: Human, Mouse
-
分类: 科研抗体货号: P08172别名: CRN; ATC2; Lrp4; PEE5; TMPRSS10应用: IHC反应种属: Human, Mouse, Rat
-
分类: 科研抗体货号: P08152别名: HCG; LHA; FSHA; GPHa; TSHA; GPHA1; CG-ALPHA应用: WB,IHC反应种属: Human
-
分类: 科研抗体货号: P08188别名: NAP; P14L; PP8304; C20orf33; dJ633O20.1应用: WB,IHC反应种属: Human, Mouse, Rat

鄂公网安备42018502007531号
鄂公网安备42018502007531号

